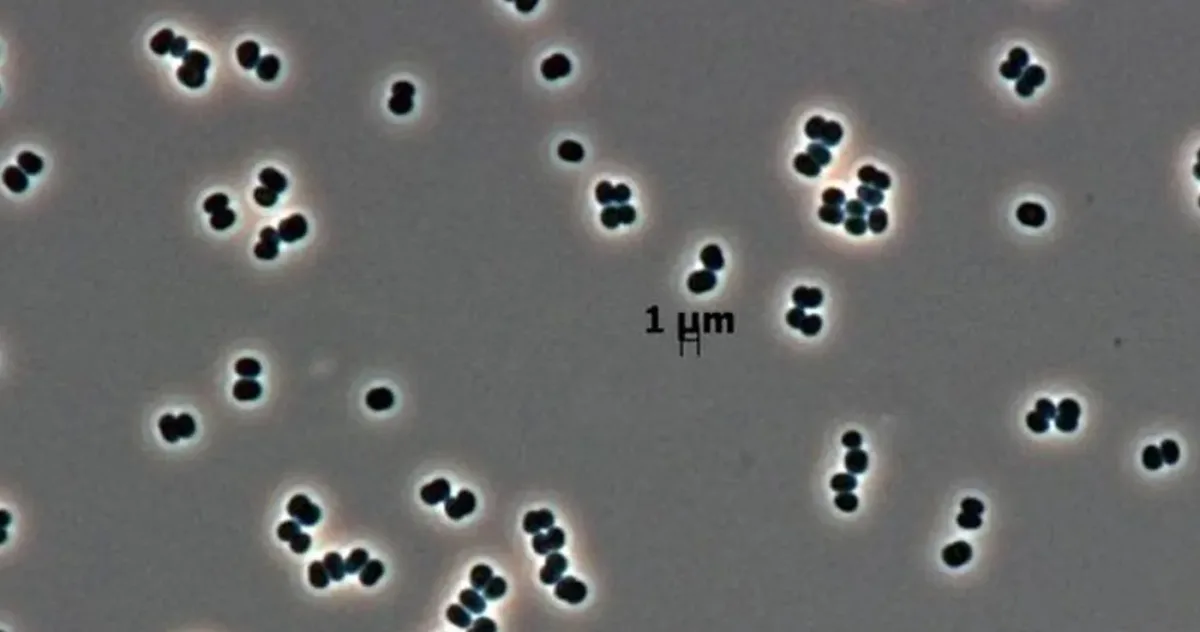
bacteriile care pot reveni la viață

Agențiile spațiale iau protecția planetară extrem de în serios. Înainte ca o navă să plece spre altă lume, aceasta este sterilizată complet. Nimeni nu vrea să contamineze un alt glob cu viață terestră sau, mai rău, să creadă că a descoperit viață extraterestră, când, de fapt, e doar un „pasager clandestin” de pe Pământ. Problema este că unele bacterii par să fie capabile să păcălească acest proces, o descoperire cu implicații majore, chiar și pentru sănătatea noastră.
Știm deja că bacteriile sunt incredibil de rezistente. Le-am găsit peste tot, de la gheizerele fierbinți din Yellowstone la lacurile înghețate de sub Antarctica. Acestea sunt „extremofilele”. Dar se pare că oamenii au creat, fără să vrea, un nou mediu extrem care forțează evoluția unor noi super-bacterii: camerele sterile folosite pentru nave spațiale. Oricât de mult s-ar strădui echipele să le curețe, bacteriile găsesc noi strategii ingenioase pentru a supraviețui.
Faceți cunoștință cu Tersicoccus phoenicis. Această bacterie a fost descoperită prima dată într-o cameră sterilă a NASA care găzduia modulul de aterizare Phoenix în anul 2007. De atunci, a mai fost găsită doar într-un singur alt loc: camera sterilă a Observatorului Spațial Herschel din Portul Spațial European. Cercetătorii au descoperit acum că această bacterie are un truc șocant: se poate preface moartă.
O formă de hibernare care păcălește sterilizarea: bacteriile care pot reveni la viață
Atunci când nutrienții lipsesc și mediul este deshidratat – exact ca în condițiile dure din camera sterilă – bacteria intră într-o stare de hibernare. Vestea morții sale este, deci, mult exagerată. Odată intrată în această stare, bacteria este și foarte greu de detectat, iar metodele standard de verificare ar putea să nu o identifice.
„Se joacă de-a v-ați ascunselea, OK? Se joacă de-a v-ați ascunselea până când găsesc condițiile potrivite. Ar putea supraviețui [mergând în spațiu și ajungând pe o altă planetă] în acest fel? Din perspectiva protecției planetare, este o preocupare reală faptul că pot supraviețui acestor condiții intrând în stare de hibernare.”, a declarat pentru publicaţia IFLScience autorul principal al studiului, profesorul asistent Madhan Tirumalai, microbiolog la Universitatea din Houston.
De ce contează descoperirea pentru sănătatea publică
Într-o cercetare finanțată de Universitatea din Houston, echipa a demonstrat că poate „readuce la viață” bacteria folosind niște compuși speciali, cunoscuți ca factori de resuscitare (RPF), de la o specie înrudită numită Micrococcus luteus.
Se pare că această abilitate de a hiberna este comună întregului filum Actinobacteria, un grup care include și temuta bacterie ce provoacă tuberculoza, o boală ce ucide 1 milion de oameni anual.
„Laboratorul nostru studiază starea de hibernare de mai mulți ani. S-a demonstrat că acest factor de resuscitare resuscitează tuberculoza, pe lângă Micrococcus luteus. Și acum se pare că poate resuscita Tersicoccus. Deci, credem că RPF-ul pe care îl avem aici ar fi un instrument bun pentru a analiza resuscitarea oricărei alte Actinobacterii latente, deoarece cred că toate au același mecanism.”, a explicat coautorul studiului, profesorul William Widger.
Implicațiile sunt uriașe. Dacă înțelegem cum bacteria tuberculozei intră în stare de latență pentru a evita antibioticele, am putea schimba radical tratamentul. Dar problema s-ar putea extinde mult dincolo de camerele sterile.
„Întrebarea mai importantă este: starea de latență este frecventă în aceste camere sterile? Aceste lecții ar putea fi aplicate și în spitale, în unitățile farmaceutice și în industria alimentară”, a adăugat Tirumalai.
Așadar, ar putea această bacterie super-rezistentă să ajungă pe Marte, sau chiar pe Titan sau Enceladus? Am pus această întrebare speculativă echipei (din care face parte și Sahr Ali, dar și George Fox, cel care a co-descoperit arheele ca un domeniu separat al vieții).
Răspunsul lor sincer? Nu știm. Încă nu cunoaștem suficient de bine proprietățile detaliate ale acelor lumi și nici toate secretele din spatele stării de hibernare și nevoilor actinobacteriilor. Este clar că sunt necesare mai multe cercetări, atât pentru implicațiile de aici, de pe Pământ, cât și pentru cele din sistemul solar.
Studiul este publicat în revista Microbiology Spectrum.












